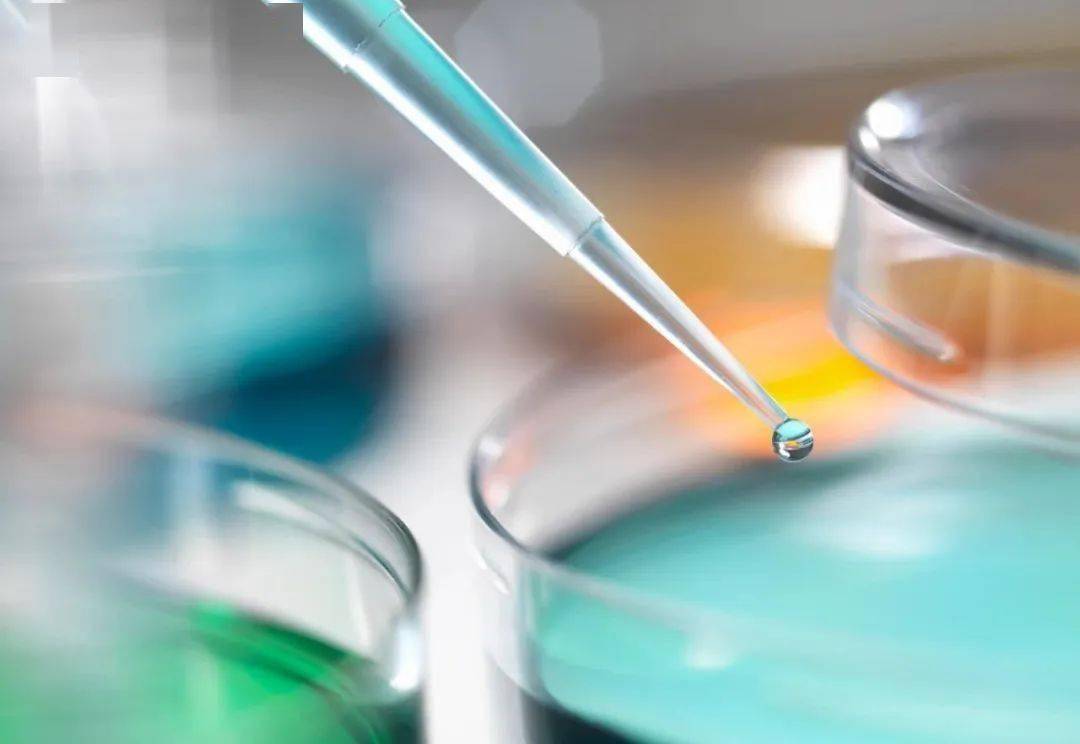

猖狂的肝癌
中国是名副其实的“肝癌大国”,肝癌的发病人数和死亡人数约占全球的50%。为什么这一癌症在我国高发?主要是因为,我们国家的肝癌高危险人群的占比非常多。
肝癌的诱发因素包括酒精、病毒性肝炎、黄曲霉素、药物滥用等多方面,其中慢性乙肝患者导致的肝癌占所有肝癌诱因高达92%以上。

肝癌是典型炎一癌转化类型肿瘤,发展规律常遵循肝炎一肝纤维化一肝硬化一肝癌的过程。近年来越来越多的研究指出,肠道菌群失调与这一过程密切相关。

肠道微生物失调
2025年1月,由香港中文大学于君团队在著名期刊《自然·微生物学》上发表一篇重要论文。她们基于肝癌患者粪便样本和小鼠模型发现:
肝癌患者的肠道微生物确实失衡,在将肝癌患者的肠菌移植给小鼠后,会导致小鼠的肠道屏障受损和活菌进入肝脏,进而促进肝癌的发生发展。
促进癌细胞繁殖
更重要的是,研究团队还证实,肠道中的肺炎克雷伯菌其实是促进小鼠肝脏炎症和肝癌发生的罪魁祸首,它会进入肝脏直接与肝癌细胞相互作用,促进细胞增殖、激活促癌信号通路。
简单来说,肠道中的肺炎克雷伯菌其实就是导致肝癌的病原体。

肠道菌辅助免疫治疗
这项研究成果证实,肝癌相关的肠道菌群失调与肝癌的发生有因果关系,且肺炎克雷伯菌是肝癌的致癌病原体。这让我们对肠菌失衡与肝癌的关系有了新认知,也为肝癌的防治提供了新思路。
其实除了肝癌的发生,肠道菌在肝癌的免疫治疗中也有非常重要的作用。双歧杆菌、乳杆菌等很多益生菌,都被发现和肝癌免疫治疗获得较好的疗效相关。

有益菌、有害菌平衡
我们知道肠道菌群是从出生就有的,后来随着饮食习惯等各种原因,慢慢发生改变而形成不同的肠道菌属。

肠道菌群主要由两类微生物组成,有益菌,比如双歧杆菌、乳酸杆菌等;有害菌,比如大肠杆菌,以及上文提到的肺炎克雷伯菌等。两类微生物的数量存在一定的平衡,共同维持肠道正常生理功能。

合理补充益生菌
肠道微生物尤其是细菌分布的平衡对人体的健康非常重要,如何调节我们的肠道菌群?
可以通过益生菌来实现。科学合理补充益生菌,让有益菌和有害菌维持长期平衡,有助于增强免疫功能和减轻炎症反应。

健康饮食是关键
此外,我们还知道食物会影响肠道微生物的组成,进而影响人体健康。比如长期高脂饮食会导致菌群失调,促进非酒精性脂肪性肝病和糖尿病的发生。